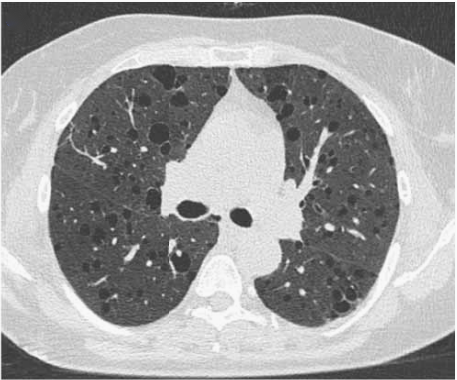
图片

一文盘点:三种不可忽视的少见间质性肺疾病
间质性肺疾病(Interstitial lung diseases,ILDs)是多样而复杂的,诊断和治疗通常有一定挑战,临床上有时对少(罕)见的ILD会识别和诊断不足。本文整理了肺泡蛋白沉积症 (pulmonary alveolar proteinosis,PAP)、胸膜肺实质弹力纤维增生症(pleuroparenchymal fibroelastosis,PPFE)和淋巴管平滑肌瘤病(Lymphangioleiomyomatosis,LAM)的诊疗要点,以飨读者。
(pulmonary alveolar proteinosis,PAP)、胸膜肺实质弹力纤维增生症(pleuroparenchymal fibroelastosis,PPFE)和淋巴管平滑肌瘤病(Lymphangioleiomyomatosis,LAM)的诊疗要点,以飨读者。
PAP是一种罕见的肺弥漫性疾病,发病率约为百万分之七,其特征为肺泡巨噬细胞功能失调致表面活性蛋白和脂质沉积于肺泡内。
PAP从发病机制上来说主要分为两种即肺泡表面活性物质的清除障碍或产生异常。表面活性物质的清除主要是通过肺泡Ⅱ型上皮细胞循环及分解代谢或者巨噬细胞的摄取来完成的。其中,巨噬细胞需要通过粒细胞-巨噬细胞集落刺激因子(granulocyte-macrophage colony-stimulating factor, GM-CSF)在肺中成熟,从而承担清除表面活性物质的作用。
PAP主要分为三类即原发性PAP(自身免疫性PAP和遗传性PAP)、继发性PAP及先天性PAP,其中90%为自身免疫性PAP。原发性PAP是由于GM-CSF信号通路中断所致。先天性PAP是由编码表面活性物质蛋白或参与表面活性物质产生的蛋白的基因突变,导致表面活性物质产生障碍引起的,多见于儿童。
继发性PAP常继发于血液系统疾病、慢性感染、有毒物质的吸入、恶性肿瘤、免疫缺陷、慢性炎症及影响单核吞噬细胞数量或功能的突变(如GATA2突变)。其致病机制尚不清楚,可能为肺泡巨噬细胞数量或功能的改变,导致肺泡巨噬细胞清除表面活性物质能力受损引起。
任何年龄均可发病,男性多于女性(2.65:1),诊断中位年龄为39岁,72%的患者有吸烟史。PAP发病隐匿,常无特征性表现。约1/3的患者可无症状,部分患者可有轻微咳嗽 、咳少许白黏痰,病情进展时可出现活动后气促,其他少见的症状有乏力、体重减轻等。继发感染时,可出现发热
、咳少许白黏痰,病情进展时可出现活动后气促,其他少见的症状有乏力、体重减轻等。继发感染时,可出现发热 、脓性痰,也可出现胸痛
、脓性痰,也可出现胸痛 、咯血
、咯血 等。体格检查可无阳性体征或肺底可闻及少许湿啰音,如出现明显湿啰音则提示合并感染可能。严重缺氧的患者可出现发绀
等。体格检查可无阳性体征或肺底可闻及少许湿啰音,如出现明显湿啰音则提示合并感染可能。严重缺氧的患者可出现发绀 、杵状指(趾)。
、杵状指(趾)。
PAP患者症状不典型,诊断主要依据影像学及组织病理结果。胸部影像学特别是出现磨玻璃影、地图征、铺路石征等典型表现需高度怀疑 PAP(图1),但需要和肺水肿 、肺真菌病
、肺真菌病 、卡氏肺抱子菌肺炎、外源性变应性肺泡炎、结节病
、卡氏肺抱子菌肺炎、外源性变应性肺泡炎、结节病 等疾病相鉴别。经支气管镜肺活检
等疾病相鉴别。经支气管镜肺活检 或外科肺活检组织病理学示肺泡腔内出现PAS和PAS-D染色阳性的嗜伊红物质可确诊为PAP。
或外科肺活检组织病理学示肺泡腔内出现PAS和PAS-D染色阳性的嗜伊红物质可确诊为PAP。

图1 a&b 37岁PAP患者的CT和胸片(同一日期)。a.铺路石征;b.双肺实变。c&d同一患者的支气管肺泡灌洗(bronchoalveolar lavage, BAL)。c.典型的BAL,呈乳白色外观。d.BAL细胞学表现为泡沫状巨噬细胞、细胞碎屑和PAS阳性细胞外小体。
PAP的首选治疗仍为全肺灌洗,目前仍缺乏关于此操作的标准化指导,大家较普遍认为进行该操作的合理指征为氧合降低,肺功能下降及影像学恶化。全肺灌洗常见的并发症包括:灌洗液溢漏至非灌洗侧肺、低氧血症、支气管痉挛 、胸腔积液
、胸腔积液 、气胸、液气胸和肺部感染。对于严重呼吸困难
、气胸、液气胸和肺部感染。对于严重呼吸困难 的患者,可以在进行体外膜肺氧合的基础上进行全肺灌洗。
的患者,可以在进行体外膜肺氧合的基础上进行全肺灌洗。
药物治疗主要用于自身免疫PAP患者,通过外源给予足够的GM-CSF来中和GM-CSF自身抗体,以达到治疗的目的。GM-CSF的给药方式主要有皮下注射及吸入两种,但应优先选择雾化吸入GM-CSF疗法,其在疗效和安全性方面优于前者。
此外,自身免疫性 PAP体内存在高水平抗 GM-CSF抗体,通过血浆置换 去除GM-CSF抗体或使用利妥昔单抗
去除GM-CSF抗体或使用利妥昔单抗 耗竭B淋巴细胞也可能成为有效治疗方法,目前其安全性和有效性仍待进一步研究。
耗竭B淋巴细胞也可能成为有效治疗方法,目前其安全性和有效性仍待进一步研究。
对于继发性PAP来说,主要的治疗策略是治疗原发病。大多数继发性PAP是由于血液疾病引起的,有病例报道表明通过骨髓移植治疗原发病的同时治疗了继发性PAP。
7.9%-29%的 PAP 患者可以自行缓解。其余大部分患者需要进行全肺灌洗,全肺灌洗应用于临床治疗后,提高了患者5年生存率。继发性PAP与较高的死亡率相关,特别是存在基础血液疾病的患者。
PPFE是一种罕见的间质性肺炎 ,其特点是上肺和胸膜下纤维化,累及脏层胸膜和胸膜下肺实质,包括肺泡壁的显著弹性纤维增生和胸膜纤维增厚。
,其特点是上肺和胸膜下纤维化,累及脏层胸膜和胸膜下肺实质,包括肺泡壁的显著弹性纤维增生和胸膜纤维增厚。
PPFE虽然较少见,但在ILD转诊中心会定期诊断出这种病例。在回顾性研究中,7.7%的特发性间质性肺炎、25%登记肺移植 的纤维化ILD、0.28%-1.9%的肺移植受者和7.5%的造血干细胞移植
的纤维化ILD、0.28%-1.9%的肺移植受者和7.5%的造血干细胞移植 受者的以PPFE为主要影像学表现。
受者的以PPFE为主要影像学表现。
PPFE可为特发性,也可继发于肺或肝移植 、造血干细胞移植、烷化剂药物、放疗、结缔组织疾病、纤维化过敏性肺炎
、造血干细胞移植、烷化剂药物、放疗、结缔组织疾病、纤维化过敏性肺炎 、特发性肺纤维化
、特发性肺纤维化 (Idiopathic pulmonary fibrosis,IPF)等特发性间质性肺炎、环境暴露、端粒相关基因突变、复发性呼吸道感染
(Idiopathic pulmonary fibrosis,IPF)等特发性间质性肺炎、环境暴露、端粒相关基因突变、复发性呼吸道感染 等。此外,PPFE样特征可出现在各种纤维化性ILD中,包括IPF、纤维化过敏性肺炎、系统性硬化症
等。此外,PPFE样特征可出现在各种纤维化性ILD中,包括IPF、纤维化过敏性肺炎、系统性硬化症 相关ILD和类风湿关节炎
相关ILD和类风湿关节炎 相关ILD,且预后较差。
相关ILD,且预后较差。
PPFE主要见于30-60岁人群(尤其女性),与吸烟无关。其发病隐匿,可有进行性呼吸短促、干咳、胸痛、体重减轻,最终出现恶病质。约40%病例听诊可闻细湿啰音,15%-20%存在杵状指,约50%出现胸廓扁平。25%-60%的患者可发生气胸或纵隔气肿,可能是首次出现也可能继发于肺活检;其中一半以上患者会复发气胸。
PPFE的胸部CT通常显示容积减少、胸膜和胸膜下致密实变并伴有网状影、结构扭曲和牵拉性支扩,主要集中于上肺(图2)。PPFE通常厚度大于5mm,且通常为进行性。上肺区PPFE的模式可与肺底普通间质性肺炎(usual interstitial pneumonia,UIP)模式相关。

图2 23岁PPFE女性患者,CT显示上肺区胸膜增厚和胸膜下实变,伴左侧自发性气胸 。
。
PPFE的肺活检病理显示胸膜下肺泡内纤维化和弹性组织增生,胸膜增厚,弹性纤维致密胶原沉积。PPFE的诊断通常通过胸部CT特征和组织病理学结果或胸部CT特征和疾病进展的影像学表现来确认;在多学科讨论中越来越多地使用后者来支持PPFE的诊断。
肺康复和肺移植治疗PPFE经验仍然有限,肺移植是唯一能治愈PPFE的方法。目前尚未对药物治疗进行前瞻性评估。患者常接受小剂量糖皮质激素 治疗,出于对感染风险的考虑,不鼓励更高剂量的皮质类固醇和二线免疫抑制剂治疗。在伴有纤维化进行性ILD的PPFE病例中,可考虑使用抗纤维化药物。
治疗,出于对感染风险的考虑,不鼓励更高剂量的皮质类固醇和二线免疫抑制剂治疗。在伴有纤维化进行性ILD的PPFE病例中,可考虑使用抗纤维化药物。
回顾性研究显示病程具有异质性,中位生存时间为35-96个月。死亡的主要原因是慢性高碳酸血症性呼吸衰竭 、肺纤维化急性加重、恶病质、吸入性肺炎
、肺纤维化急性加重、恶病质、吸入性肺炎 和肺栓塞
和肺栓塞 。
。
LAM是一种罕见的以双肺弥漫性囊性变为主要特征的多器官受累肿瘤性疾病,可散发或与结节性硬化症 (tuberous sclerosis complex,TSC)相关。LAM的特征是存在来自未知来源的异常平滑肌细胞并浸润组织。几乎所有病例均发生于女性,尤其是育龄期女性,约每百万人中有五人发病,但也偶有成年男子发病的报告。2/3LAM病例是散发性的。在TSC患者中,LAM的患病率随年龄增加,在40岁时达到81%。
(tuberous sclerosis complex,TSC)相关。LAM的特征是存在来自未知来源的异常平滑肌细胞并浸润组织。几乎所有病例均发生于女性,尤其是育龄期女性,约每百万人中有五人发病,但也偶有成年男子发病的报告。2/3LAM病例是散发性的。在TSC患者中,LAM的患病率随年龄增加,在40岁时达到81%。
LAM临床症状没有特异性,通常表现为劳动性呼吸困难、咳嗽、自发性气胸、乳糜胸、咯血和胸痛等。气胸和乳糜胸常为LAM的首发症状,并可反复发生。部分患者可同时伴有腹部肿瘤,包括血管平滑肌脂肪瘤和淋巴管肌瘤。其肺功能异常表现为阻塞性通气功能障碍。
LAM的HRCT有典型的特征性改变,主要表现为双肺弥漫性薄壁囊性改变(图3)。囊性病变的直径在数毫米至数厘米。其他发现包括磨玻璃影、小叶间隔增厚、气胸和胸腔积液。
图3 散发性LAM患者的HRCT显示多个双侧分布的数厘米的薄壁囊肿
根据美国胸科协会和日本呼吸学会2017年发布的LAM临床实践指南,LAM确诊标准为:符合LAM的临床病史和肺部HRCT特征;同时具备以下一个或多个特征。
● 结节性硬化症
● 肾血管平滑肌脂肪瘤
● 乳糜胸或乳糜腹水
● 淋巴管平滑肌瘤
● 血清血管内皮细胞生长因子-D(VEGF-D)≥800pg/ml
● 在浆膜腔积液 或淋巴结中发现LAM细胞或LAM细胞簇
或淋巴结中发现LAM细胞或LAM细胞簇
● 组织病理证实为LAM(肺、腹膜后、或盆腔肿瘤)
LAM发病机制的分子基础是TSC2基因突变和mTOR信号通路的过度激活。西罗莫司 (雷帕霉素)由于能够特异性抑制mTOR活性,被列为LAM治疗的首选药物。另一个mTOR抑制剂依维莫司
(雷帕霉素)由于能够特异性抑制mTOR活性,被列为LAM治疗的首选药物。另一个mTOR抑制剂依维莫司 似乎同样有效,一些治疗LAM药物尚在研究中。鉴于气胸复发率高,首次发作后应考虑胸膜固定术。对于终末期呼吸衰竭,肺移植是可行的选择,据报道中位生存期为12年。
似乎同样有效,一些治疗LAM药物尚在研究中。鉴于气胸复发率高,首次发作后应考虑胸膜固定术。对于终末期呼吸衰竭,肺移植是可行的选择,据报道中位生存期为12年。
LAM呈慢性病程,即使病变程度严重的患者,静息或氧疗 状态下患者可无明显的呼吸困难表现。10年和20年无肺移植生存率分别约为85%和64%。
状态下患者可无明显的呼吸困难表现。10年和20年无肺移植生存率分别约为85%和64%。
参考文献:
1. Buschulte K, Cottin V, et al. The world of rare interstitial lung diseases. Eur Respir Rev. 2023 Feb 7;32(167):220161.
2. 王天真,曹孟淑.肺泡蛋白沉积症的诊治进展[J].临床肺科杂志,2022,27(04):598-602.
3.陈荣昌 ,钟南山
,钟南山 ,刘又宁
,刘又宁 等.呼吸病学,第3版.北京:人民卫生出版社,2022年.
等.呼吸病学,第3版.北京:人民卫生出版社,2022年.
4. 徐文君,张建全,周黄超 等.肺淋巴管平滑肌瘤病2例病例报道并文献复习[J].临床肺科杂志,2023,28(06):965-970.
等.肺淋巴管平滑肌瘤病2例病例报道并文献复习[J].临床肺科杂志,2023,28(06):965-970.
 ,助力中国临床决策”是平台的使命。医脉通旗下拥有「临床指南」「用药参考」「医学文献王」「医知源」「e研通」「e脉播」等系列产品,全面满足医学工作者临床决策、获取新知及提升科研效率等方面的需求
,助力中国临床决策”是平台的使命。医脉通旗下拥有「临床指南」「用药参考」「医学文献王」「医知源」「e研通」「e脉播」等系列产品,全面满足医学工作者临床决策、获取新知及提升科研效率等方面的需求